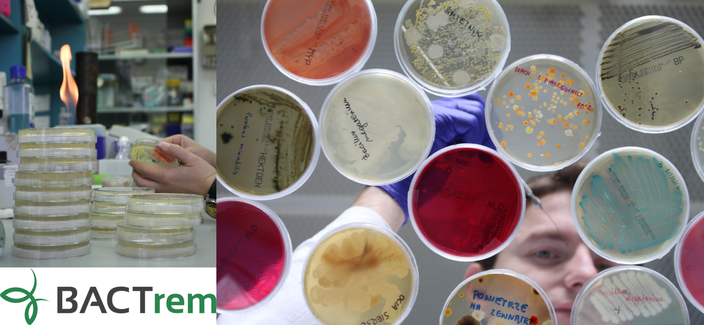

Raport (pełna wersja dostępna na: https://ekobarometr.pl/ekobarometr-7) obejmuje aż 9 obszarów tematycznych w tym – POSTAWY EKOLOGICZNE. W podsumowaniu tego obszaru pt.:„JAK SPRAWIĆ BY BYCIE EKO STAŁO SIĘ STYLEM ŻYCIA?” prof. Magdalena Popowska – Prezeska i Założycielka firmy BACTrem (na podstawie całego Raportu jak i odpowiedzi udzielonych na specjalne pytania przygotowane przez BACTrem), komentuje otrzymane wyniki: Wiedza dotycząca ekologii jest na dobrym poziomie, respondenci wiedzą co to pojęcie oznacza, ale ich własne postępowanie i działania proekologiczne oraz firm w których pracują są raczej efektem związanym z oszczędnością oraz wymogami prawnymi i administracyjnymi, niż osobistymi przekonaniami i chęcią bycia EKO. Zapewne ma to związek z wartościami jakie cenią: wolność i komfort życia. Jednocześnie ponad połowa respondentów zdrowie, rodzinę i bezpieczeństwo uważa za najważniejsze. Zatem można pokusić się o wniosek, że badani nie posiadają odpowiedniej wiedzy na temat zagrożeń środowiskowych - nie dlatego, że nie chcą jej zdobyć bo przecież cenią sobie wiedzę i edukację, ale dlatego, że nikt takiej odpowiedniej wiedzy im nie dostarcza. Świadczą o tym również odpowiedzi już na konkretnie postawione pytania, wtedy większość odpowiada, że ‘nie wie’ lub ‘ciężko powiedzieć’.
Bardzo pozytywnym aspektem jest to, że większość respondentów segreguje śmieci, wyłącza światło i nie używany sprzęt, wykorzystuje deszczówkę, piecze chleb, naprawia sprzęty i ubrania, robi zakupy rzadziej i w przemyślany sposób oraz używa własnych toreb. Ponad 30% ankietowanych twierdzi, że główną motywacją w podejmowaniu takich działań jest ekonomia i ekologia, a 1/4, że tylko ekonomia, czyli szukanie oszczędności. Z danych można wnioskować, że respondenci deklarują niewystarczającą wiedzę i niską znajomość działań praktycznych, istnieje luka między świadomością a codziennym działaniem. Pozytywny aspekt to otwarcie części społeczeństwa na zmiany, ale pod warunkiem wsparcia (np. ekonomicznego, infrastrukturalnego, informacyjnego). Zatem jak sprawić, by bycie EKO nie było tylko modą, zakłamaną reklamą dla chęci zysku ale STYLEM ŻYCIA? Odpowiedź jest tyko jedna: edukować, informować i nagłaśniać - co BACTrem stara się również aktywnie robić.
Polacy coraz rzadziej stawiają ekologię na pierwszym miejscu. Tym bardziej rośnie znaczenie firm, które nie tylko analizują skalę tego zjawiska, lecz także wdrażają konkretne i innowacyjne rozwiązania na rzecz jego ochrony.Jedną z nich jest BACTrem – spółka biotechnologiczna. Prof. Magdalena Popowska - założycielka i Prezeska spółki często wypowiada się na temat konsekwencji społecznej obojętności oraz o tym, jak nauka może przełożyć się na praktyczne działania na rzecz ekologii i ochrony środowiska.
Współpraca BACTrem z projektem EKObarometr to symboliczne połączenie deklaracji społecznych z realnym działaniem. Wyniki badań pokazują niepokojący trend – rosnącą obojętność i niski poziom wiedzy ekologicznej Polaków. To sygnał ostrzegawczy, który wymaga konkretnych działań: skutecznych regulacji, praktycznych rozwiązań i edukacji.
Firma BACTrem Sp. z o.o., powstała w 2016 r., wywodzi się z Uniwersytetu Warszawskiego i wykorzystuje pożyteczne (funkcjonalne) mikroorganizmy do oczyszczania środowiska. Prof. Magdalena Popowska, biotechnolog i mikrobiolog oraz ekspertka w dziedzinie biotechnologii środowiskowej, często wspiera projekty edukacyjne i medialne dotyczące problemów ekologicznych. Spółka działa niezależnie od 2019 r., posiada własne kadry, zaplecze laboratoryjno-produkcyjne i muzeum mikroorganizmów, w których przechowuje szczepy o pożytecznych właściwościach. Firma dąży do zminimalizowania negatywnego wpływu niebezpiecznych odpadów na środowisko, oferując nowoczesne i efektywne metody ich utylizacji. Odpowiada na potrzeby środowiska i rolnictwa proekologicznego z naukową precyzją, tworząc nowe specjalistyczne i bezpieczne biopreparaty (z Atestem NIZP-PZH) o celowanym działaniu jak również opracowując innowacyjne rozwiązania biotechnologiczne. Oferuje biopreparaty do biodegradacji związków toksycznych (jak związki ropopochodne czy składowe oleju kreozotowego), do usuwania zanieczyszczeń z gleby i wód lub przetwarzania odpadów.
Dla sektora rolnego opracowała serię specjalistycznych biopreparatów (seria BIOSTIM) do rekultywacji zdegradowanych terenów rolnych. Jeden z nich usuwa fitopatogeny – mikroorganizmy wywołujące choroby roślin, inny rozkłada pestycydy, w tym glifosat, przywracając glebie naturalną równowagę mikrobiologiczną. Kolejny preparat wspiera strefę korzeniową roślin i zwiększa żyzność, a specjalny środek do kompostowania przyspiesza rozkład materii organicznej. Preparaty z serii BIOSTIM przywracają naturalny mikrobiom gleby i odpowiednie pH, dzięki czemu przyczyniają się do powstania próchnicy. Zwiększają właściwości sorpcyjne gleby, przez co zapobiegają skutkom suszy. Aktywnie wspomagają rozwój korzeni wspierając wzrost roślin. W konsekwencji - efektywnie zwiększają ilości plonów w sposób naturalny.
BACTrem posiada również szeroką ofertę badań mikrobiologicznych, w tym niestandardowych materiałów i produktów przemysłowych oraz leczniczych, zgodnie z potrzebami klientów.
Firma specjalizuje się też w rozwiązywaniu nietypowych problemów badawczych oraz prowadzeniu prac B+R odpowiadając na zagrożenia środowiskowe oraz potrzeby klientów. Opracowała i wdrożyła m.in. technologie do przetwarzania: odpadów drewnianych, impregnowanych kreozotem, szlamów zawierających substancje niebezpieczne oraz przefermentowanych odpadów. Proponowane rozwiązania i technologie pozwalają na prowadzenie działań zgodnie z zasadą zrównoważonego rozwoju, np.: ograniczenie emisji zanieczyszczeń, ochronę bioróżnorodności i racjonalne gospodarowanie zasobami. Wpisują się również w strategię „Zero Waste” umożliwiając eliminację niebezpiecznych odpadów i materiałów, zmniejszenie ich objętości a także ich przetwarzanie i odzyskiwanie tak, aby ponownie można je było wykorzystać jako surowiec.
Największym dotychczasowym osiągnieciem firmy BACTrem jest opracowanie i wdrożenie (na podstawie udzielonej licencji) innowacyjnej technologii przetwarzania i utylizacji drewnianych odpadów impregnowanych z wykorzystaniem oleju kreotyzowego. Mowa o całych lub pofragmentowanych podkładach kolejowych i słupach ogrodzeniowych. Proces polega na oczyszczeniu drewna poprzez wymycie oleju kreozotowego z wykorzystaniem specjalnego roztworu i urządzeń grzewczo-ciśnieniowych, a następnie biodegradacji wszystkich wymytych zanieczyszczeń z wykorzystaniem unikatowego biopreparatu bakteryjnego. Efektem końcowym całego procesu jest surowiec drzewny spełniający normy. Technologia została wdrożona i działa na terenie Nasycalni Podkładów w Pludrach (woj. opolskie), jedynym w Polsce zakładzie posiadającym zintegrowane pozwolenie na taką działalność. BACTrem dostarcza niezbędne preparaty oraz prowadzi nadzór merytoryczny nad procesem. Najważniejszą nowością rozwiązania jest kompleksowość tej technologii, która łączy metody fizyczne, chemiczne i biologicznie.
Wszystkie etapy technologii oraz niezbędne preparaty zostały opracowane przez Firmę BACTrem i posiadają Atesty. Technologia nie prowadzi do wytworzenia nowych odpadów w tym niebezpiecznych, charakteryzuje się niskoemisyjnym charakterem, co jest zgodne z koncepcją Zero Waste i Zrównoważonego Rozwoju. Brak podobnej technologii na rynku - aktualny stan techniki oraz rozpoznanie rynku (polskiego i europejskiego) potwierdza, iż nie została wdrożona podobna technologia prowadząca do odzysku surowca.
Jak podkreśla prof. Magdalena Popowska, ekonomia wciąż odgrywa kluczową rolę w kształ-towaniu postaw proekologicznych. – Na końcu zawsze są pieniądze. Firmy angażują się w eko-innowacje nie z powodu idei, lecz dlatego, że przekładają się one na oszczędności i rozwój nowych technologii co oznacza nowe sposoby zarabiania. Przykładem takiego podejścia jest wdrożenie technologii utylizacji drewnianych odpadów impregnowanych kreozotem – tam interesy środowiska i biznesu spotkały się w jednym punkcie.
Firma za swoją działalność jest często nagradzana – m.in. otrzymała w 2022 roku Nagrodę Główną Rzeczypospolitej „Zielony Orzeł”, której kapituła doceniła działania firmy na rzecz ochrony środowiska naturalnego. W 2020 roku została wyróżniona w Rankingu Odpowiedzialnych Firm oraz Startupów Pozytywnego Wpływu przez Akademię Leona Koźmińskiego za „prowadzenie innowacyjnych, zakończonych wdrożeniem prac badawczych, które rozwiązują istotne wyzwania społeczne. Zdaniem jury konkursu BACTrem Sp. z o.o. potrafi doprowadzić do wzrostu wartości organizacji, a jednocześnie podnieść jakość życia ludzi i środowiska; tworzy wartość poprzez innowacje na rzecz zrównoważonego rozwoju”. W 2025 roku firma BACTrem została laureatem konkursu "Innowator Mazowsza”. Kapituła pod przew. Marszałka Województwa podjęła ostateczne decyzje o wyborze laureatów na podstawie innowacyjnych rozwiązań wdrożonych przez uczestników konkursu oraz ich pozytywnym wpływie na ludzi, środowisko lub lokalny ekosystem. Więcej na www.bactrem.pl
Partnerem publikacji jest: Rzecz o innowacji